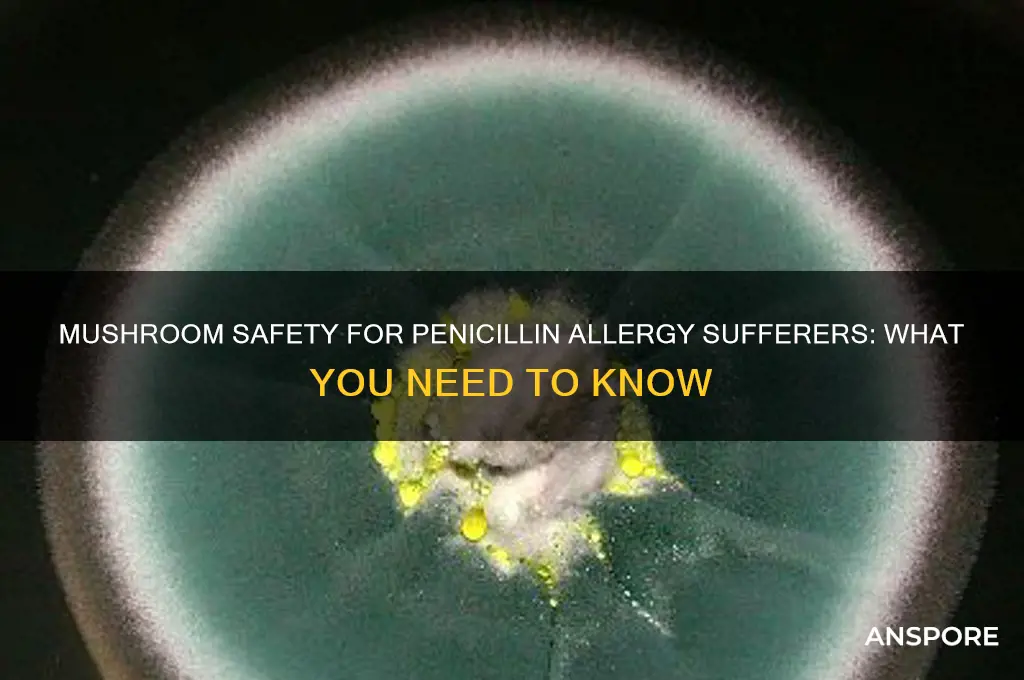
can i eat mushrooms if i

Many people wonder if they can safely eat mushrooms if they have a penicillin allergy, given that both are fungi. While penicillin is derived from a specific type of mold, mushrooms belong to a different fungal group and are not directly related to penicillin production. However, some individuals with penicillin allergies may also react to other fungi or molds due to cross-reactivity. Although rare, it’s possible for certain mushroom species to trigger allergic symptoms in sensitive individuals. If you have a penicillin allergy, it’s advisable to consult a healthcare professional before consuming mushrooms, especially if you’ve never tried them before or have a history of multiple allergies. Always start with a small amount to monitor for any adverse reactions.
| Characteristics | Values |
|---|---|
| Cross-Reactivity Risk | Low; mushrooms and penicillin are not closely related biologically. |
| Allergic Reaction Potential | Unlikely, as mushroom allergies are distinct from penicillin allergies. |
| Common Allergens in Mushrooms | Proteins specific to fungi, not related to penicillin. |
| Medical Consensus | Generally safe to eat mushrooms if allergic to penicillin. |
| Precautionary Advice | Consult a healthcare provider if unsure or if severe allergies exist. |
| Exceptions | Rare cases of cross-reactivity may exist but are not well-documented. |
| Alternative Concerns | Some mushrooms may interact with medications; check with a doctor. |
| Source Reliability | Based on current medical research and allergist recommendations. |
| Key Takeaway | Mushrooms are typically safe for penicillin-allergic individuals. |
Explore related products
What You'll Learn
- Cross-Reactivity Risks: Do mushrooms share penicillin allergy triggers
- Types of Mushrooms: Are all mushrooms safe for penicillin-allergic individuals
- Symptoms to Watch: What allergic reactions might occur with mushrooms
- Medical Advice: Should penicillin-allergic people consult doctors before eating mushrooms
- Alternative Fungi: Are there safer mushroom substitutes for penicillin allergies

Cross-Reactivity Risks: Do mushrooms share penicillin allergy triggers?
Mushrooms and penicillin are both fungi, which raises concerns about cross-reactivity in individuals with penicillin allergies. While this shared biological classification might suggest a potential risk, the scientific consensus is reassuring. Studies indicate that true cross-reactivity between penicillin and mushrooms is extremely rare. The allergens in penicillin are structurally distinct from those found in mushrooms, making adverse reactions unlikely for most people. However, exceptions exist, particularly for those with severe mold or fungal allergies, who may experience unrelated sensitivities.
For individuals with penicillin allergies, the decision to consume mushrooms should be guided by personal medical history and professional advice. Allergic reactions to penicillin typically stem from specific proteins in the antibiotic, not from its fungal origin. Mushrooms contain different proteins and compounds, such as beta-glucans, which are generally well-tolerated. However, some people may mistake mild gastrointestinal discomfort from mushrooms (e.g., bloating or gas) for an allergic reaction. Distinguishing between intolerance and allergy is crucial, as the latter requires immediate medical attention.
Practical steps can help penicillin-allergic individuals navigate mushroom consumption safely. Start with a small portion of a common variety, like button or cremini mushrooms, and monitor for symptoms over 24 hours. If no adverse reactions occur, gradually increase the amount. Avoid exotic or wild mushrooms, as they may contain unique compounds that could trigger unrelated sensitivities. Always consult an allergist before reintroducing any potentially reactive food, especially if your penicillin allergy is severe or if you have a history of multiple drug allergies.
While cross-reactivity between penicillin and mushrooms is rare, individual variability underscores the need for caution. Factors like age, immune system strength, and pre-existing conditions can influence how one reacts to foods. For instance, older adults or those with compromised immunity may be more susceptible to adverse effects. Keeping a food diary can help track reactions and identify patterns. Ultimately, the key is to approach mushroom consumption thoughtfully, balancing scientific evidence with personalized health considerations.
Death Cap Mushrooms: Deadly Threat to Dogs and Prevention Tips
You may want to see also

Types of Mushrooms: Are all mushrooms safe for penicillin-allergic individuals?
Mushrooms and penicillin allergies are often discussed in the same breath, but the connection isn’t as straightforward as it seems. While both originate from fungi, not all mushrooms produce compounds similar to penicillin. For instance, *Penicillium* molds, the source of penicillin, are distinct from edible mushrooms like button, shiitake, or oyster mushrooms. However, some wild mushrooms, such as those in the *Penicillium* genus, can produce mycotoxins or compounds that might trigger reactions in sensitive individuals. Understanding this distinction is crucial for penicillin-allergic individuals navigating mushroom consumption.
Analyzing the risk, it’s essential to differentiate between cultivated and wild mushrooms. Cultivated varieties, commonly found in grocery stores, are generally safe for penicillin-allergic individuals. These mushrooms are grown in controlled environments, minimizing exposure to cross-contamination or mold-related compounds. However, wild mushrooms pose a higher risk due to their unpredictable nature. Some species, like the *Clitocybe* genus, can produce toxins that mimic allergic reactions, though these are not directly related to penicillin. Always consult a healthcare professional before consuming wild mushrooms, especially if you have a history of allergies.
For practical guidance, start by sticking to well-known, commercially grown mushrooms. Button, cremini, portobello, shiitake, and oyster mushrooms are safe choices. Avoid foraging for wild mushrooms unless you’re an expert or working with a mycologist. If you experience symptoms like itching, swelling, or digestive discomfort after eating mushrooms, discontinue use and seek medical advice. Additionally, consider keeping a food diary to track reactions and identify potential triggers. While rare, cross-reactivity between mushrooms and penicillin is possible, so caution is key.
Comparatively, the risk of mushroom consumption for penicillin-allergic individuals is lower than that of other foods, such as fermented products like blue cheese or certain aged meats, which can contain penicillium molds. However, the variability in mushroom species and growing conditions necessitates vigilance. For example, mushrooms grown in mold-prone environments might carry traces of mold spores, though this is uncommon in commercial products. Opting for organic, certified mushrooms can further reduce this risk by ensuring stricter cultivation standards.
In conclusion, not all mushrooms are created equal when it comes to penicillin allergies. Cultivated varieties are generally safe, while wild mushrooms require careful consideration. By focusing on reputable sources, avoiding wild foraging, and monitoring for adverse reactions, penicillin-allergic individuals can safely enjoy mushrooms as part of a balanced diet. Always prioritize expert advice and err on the side of caution when in doubt.
Are Store-Bought Mushrooms Psychedelic? Unveiling the Truth Behind Your Groceries
You may want to see also

Symptoms to Watch: What allergic reactions might occur with mushrooms?
Mushroom allergies, though less common than other food allergies, can trigger reactions ranging from mild to severe. If you’re allergic to penicillin, cross-reactivity with mushrooms is rare but not impossible, as both belong to the fungal kingdom. However, the primary concern lies in recognizing allergic symptoms specific to mushrooms, which can manifest differently from person to person. Understanding these symptoms is crucial for timely intervention and prevention of complications.
Immediate Symptoms to Monitor: Within minutes to hours of consuming mushrooms, watch for signs like itching or swelling of the lips, tongue, or throat, hives, or eczema-like rashes. These are classic indicators of an IgE-mediated allergic reaction, where the immune system overreacts to mushroom proteins. In severe cases, gastrointestinal symptoms such as nausea, vomiting, abdominal pain, or diarrhea may occur. For individuals with asthma, mushroom allergies can exacerbate respiratory symptoms, leading to wheezing or shortness of breath.
Delayed Reactions and Anaphylaxis: While less common, delayed reactions can occur up to 48 hours after ingestion, presenting as persistent gastrointestinal distress or worsening skin conditions. Anaphylaxis, though rare, is life-threatening and requires immediate medical attention. Symptoms include rapid onset of difficulty breathing, a sharp drop in blood pressure, dizziness, or loss of consciousness. If you experience tightness in the chest, difficulty swallowing, or a rapid heartbeat after eating mushrooms, seek emergency care promptly.
Practical Tips for Monitoring: Keep an allergy diary to track symptoms after mushroom consumption, noting the type and amount eaten. For those with known penicillin allergies, start with a small portion (e.g., 1-2 pieces of cooked mushroom) and wait 2 hours to observe any reactions. Avoid raw mushrooms, as they may contain higher levels of allergens. If symptoms occur, discontinue consumption and consult an allergist for testing, such as skin prick tests or blood tests for specific IgE antibodies.
Prevention and Preparedness: If you’re at risk, carry an epinephrine auto-injector (e.g., EpiPen) as a precaution, especially if you have a history of severe allergies. Educate family and friends about your allergy and how to respond in an emergency. When dining out, clearly communicate your allergy to restaurant staff, as mushrooms can be hidden in sauces, soups, or stuffing. Reading food labels diligently is equally important, as processed foods may contain mushroom derivatives under names like "fungal extracts" or "mycoprotein."
By staying vigilant and informed, you can enjoy a safer relationship with mushrooms while managing potential allergic risks effectively.
Can Dogs Detect Psilocybin Mushrooms? Exploring Their Scent Abilities
You may want to see also
Explore related products

Medical Advice: Should penicillin-allergic people consult doctors before eating mushrooms?
Penicillin allergies affect approximately 10% of the population, but fewer than 1% experience true allergic reactions upon re-exposure. Despite this, many penicillin-allergic individuals avoid mushrooms due to a perceived risk of cross-reactivity. However, scientific evidence suggests that mushrooms and penicillin are structurally distinct, with no shared allergenic proteins. This raises the question: is consulting a doctor necessary before incorporating mushrooms into a penicillin-allergic diet?
From an analytical perspective, the concern stems from a misunderstanding of fungal biology. Penicillin is derived from the *Penicillium* fungus, while edible mushrooms belong to the *Basidiomycota* division. These organisms differ significantly in their metabolic pathways and protein compositions. Studies, including a 2018 review in the *Journal of Fungi*, found no immunologic cross-reactivity between penicillin and common mushrooms like button, shiitake, or oyster varieties. However, rare cases of mushroom allergies unrelated to penicillin exist, typically manifesting as oral allergy syndrome or anaphylaxis in less than 0.1% of the population.
Instructively, penicillin-allergic individuals should approach mushroom consumption with caution, not due to cross-reactivity fears, but to monitor for independent allergic responses. Start with a small portion (e.g., 10–20 grams of cooked mushrooms) and observe for symptoms like itching, swelling, or gastrointestinal distress over 2–4 hours. If no reaction occurs, gradually increase intake. For those with severe penicillin allergies (e.g., history of anaphylaxis), consulting an allergist before introducing mushrooms is advisable, as they can perform skin prick tests or oral food challenges to rule out unrelated sensitivities.
Persuasively, avoiding mushrooms unnecessarily deprives individuals of their nutritional benefits, including vitamins D and B, antioxidants, and fiber. A 2021 study in *Food & Function* highlighted mushrooms’ role in immune modulation, which could paradoxically benefit those with allergies. Yet, self-diagnosis is risky. A survey by the American College of Allergy, Asthma, and Immunology revealed that 50% of self-reported penicillin allergies were inaccurate, leading to over-reliance on broader-spectrum antibiotics. This underscores the importance of professional guidance to clarify allergy status before making dietary changes.
Comparatively, while penicillin-allergic individuals are often advised to avoid certain fermented foods (e.g., blue cheese, soy sauce) due to potential fungal contamination, mushrooms are a different case. Unlike these foods, which may contain trace *Penicillium* spores, commercially cultivated mushrooms are grown in controlled environments, minimizing cross-contamination risks. However, foraged wild mushrooms pose a higher risk due to unpredictable fungal exposure and should be avoided without expert identification.
In conclusion, penicillin-allergic individuals need not universally avoid mushrooms, but consulting a doctor is prudent, especially for those with severe reactions or uncertainty about their allergy’s scope. A personalized approach—combining medical history, allergy testing, and gradual dietary introduction—ensures safety while preserving access to mushrooms’ health benefits. Always prioritize professional advice over self-assessment to avoid unnecessary restrictions or unintended risks.
Where to Buy Mushrooms in DC: Legal Options and Tips
You may want to see also

Alternative Fungi: Are there safer mushroom substitutes for penicillin allergies?
Penicillin allergies affect approximately 10% of the population, often limiting their antibiotic options. But what about mushrooms? While both penicillin and mushrooms are fungi, their allergenic properties differ significantly. Penicillin allergies stem from specific proteins in the antibiotic, not from fungal components. Mushrooms, on the other hand, contain beta-glucans and other compounds that rarely cross-react with penicillin allergens. However, individual sensitivities vary, so caution is advised.
For those wary of mushrooms due to a penicillin allergy, alternative fungi like lion’s mane, reishi, or chaga offer safer options. These medicinal mushrooms are rich in immune-boosting compounds but lack the proteins associated with penicillin allergies. For instance, lion’s mane is often consumed in doses of 500–1,000 mg daily to support cognitive health, while reishi (1–1.5 grams daily) is prized for its stress-relieving properties. Always start with a small dose to monitor tolerance, especially if you have a history of allergies.
If you’re hesitant to consume mushrooms, consider topical applications or extracts. Mushroom-derived skincare products, like chaga serums or shiitake-infused creams, provide benefits without systemic exposure. Alternatively, opt for mushroom-based supplements in capsule form, which often undergo processing to remove potential allergens. Consult a healthcare provider before incorporating new supplements, particularly if you have severe allergies or are taking medications.
Comparatively, while penicillin allergies restrict antibiotic use, mushrooms and their derivatives rarely pose the same risks. However, cross-contamination in processing facilities could be a concern. Look for certified allergen-free products or grow your own mushrooms to ensure purity. For example, oyster mushrooms are easy to cultivate at home and offer a safe, nutritious alternative to store-bought varieties. Always prioritize transparency in sourcing to minimize risks.
In conclusion, penicillin allergies don’t necessarily mean mushrooms are off-limits. By choosing alternative fungi, starting with small doses, and opting for certified products, you can safely explore their benefits. Whether for culinary use, medicinal purposes, or skincare, mushrooms offer a versatile and largely safe option for those with penicillin sensitivities. Always monitor your body’s response and consult a professional when in doubt.
Can Fog Drown Fruiting Mushrooms? Exploring Moisture's Impact on Growth
You may want to see also
Frequently asked questions
Yes, you can generally eat mushrooms if you're allergic to penicillin. Mushrooms and penicillin are unrelated, and a penicillin allergy does not increase the risk of reacting to mushrooms.
No, there is no evidence of cross-reactivity between penicillin and mushrooms. However, if you experience symptoms after eating mushrooms, consult a doctor to rule out other allergies or sensitivities.
Not necessarily. While penicillin is derived from mold, mushrooms are a different type of fungus. However, if you have a mold allergy, consult an allergist before consuming mushrooms to ensure safety.

























